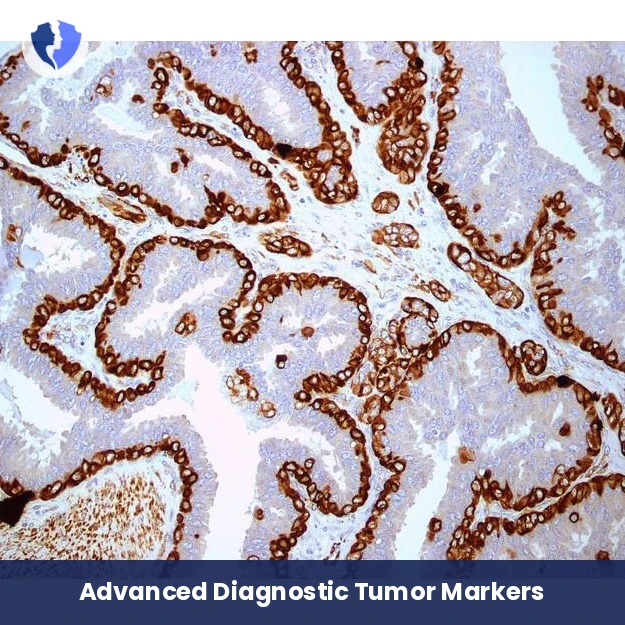
Differential Diagnosis & Environment Assessment - Immunohistochemistry (IHC) Interpretation and Consultation (

Differential Diagnosis & Environment Assessment - Immunohistochemistry (IHC) Interpretation and Consultation (6 Markers)
An advanced diagnostic and analytical consultation package based on the analysis of six carefully selected immunohistochemical (IHC) markers to achieve two main objectives: 1) Accurate differential diagnosis among tumors with similar histological appearance (e.g., differentiating small cell lung cancer from lymphoma, or differentiating different types of sarcoma). 2) Assessment of the tumor's metabolic and environmental phenotype using markers such as GLUT1 (for glycosurfactants), CAIX (for acidification), or HIF-1α (for hypoxic response). Interpretation is provided by a pathologist experienced in complex differential diagnosis, with a report identifying the most likely diagnosis and describing the tumor's environmental characteristics that may influence treatment efficacy.